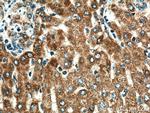
TXNRD2 Antibody in Immunohistochemistry (Paraffin) (IHC (P))

Search
Proteintech
TXNRD2 Polyclonal Antibody
{{$productOrderCtrl.translations['antibody.pdp.commerceCard.promotion.promotions']}}
{{$productOrderCtrl.translations['antibody.pdp.commerceCard.promotion.viewpromo']}}
{{$productOrderCtrl.translations['antibody.pdp.commerceCard.promotion.promocode']}}: {{promo.promoCode}} {{promo.promoTitle}} {{promo.promoDescription}}. {{$productOrderCtrl.translations['antibody.pdp.commerceCard.promotion.learnmore']}}
产品信息
16360-1-AP
种属反应
已发表种属
宿主/亚型
分类
类型
抗原
偶联物
形式
浓度
规格
纯化类型
保存液
内含物
保存条件
运输条件
产品详细信息
Immunogen sequence: EILLSADHI IIATGGRPRY PTHIEGALEY GITSDDIFWL KESPGKTLVV GASYVALECA GFLTGIGLDT TIMMRSIPLR GFDQQMSSMV IEHMASHGTR FLRGCAPSRV RRLPDGQLQV TWEDSTTGKE DTGTFDTVLW AIGRVPDTRS LNLEKAGVDT SPDTQKILVD SREATSVPHI YAIGDVVEGR PELTPIAIMA GRLLVQRLFG GSSDLMDYDN VPTTVFTPLE YGCVGLSEEE AVARHGQEHV EVYHAHYKPL EFTVAGRDAS QCYVKMVCLR EPPQLVLGLH FLGPNAGEVT QGFALGIKCG ASYAQVMRTV GIHPTCSEEV VKLRISKRSG LDPTVTGCUG (137-485 aa encoded by BC007489)
靶标信息
The mammalian thioredoxin reductases (TrxRs) are a family of selenocysteine-containing pyridine nucleotide-disulfide oxidoreductases. All the mammalian TrxRs are homologous to glutathione reductase with respect to primary structure including the conserved redox catalytic site (-Cys-Val-Asn-Val-Gly-Cys-) but distinctively with a C-terminal extension containing a catalytically active penultimate selenocysteine (SeCys) residue in the conserved sequence (-Gly-Cys-SeCys-Gly). TrxR is homodimeric protein in which each monomer includes an FAD prosthetic group, a NADPH binding site and a redox catalytic site. Electrons are transferred from NADPH via FAD and the active-site disulfide to C-terminal SeCys-containing redox center, which then reduces the substrate like thioredoxin. The members of TrxR family are 55-58 kilodalton in molecular size and composed of three isoforms including cytosolic TrxR1, mitochondrial TrxR2, and TrxR3, known as Trx and GSSG reductase (TGR). TrxR plays a key role in protection of cells against oxidative stress and redox-regulatory mechanism of transcription factors and various biological phenomena.
仅用于科研。不用于诊断过程。未经明确授权不得转售。
生物信息学
蛋白别名: Selenoprotein Z; SelZ; Thioredoxin reductase 2, mitochondrial; thioredoxin reductase 3; thioredoxin reductase beta; Thioredoxin reductase TR3; TR beta; TR-beta; unnamed protein product
基因别名: AA118373; ESTM573010; GCCD5; KIAA1652; SELZ; TGR; TR; TR-BETA; TR3; TRXR2; Trxrd2; TXNR2; TXNRD2
UniProt ID: (Human) Q9NNW7, (Mouse) Q9JLT4, (Rat) Q9Z0J5
Entrez Gene ID: (Human) 10587, (Mouse) 26462, (Rat) 50551